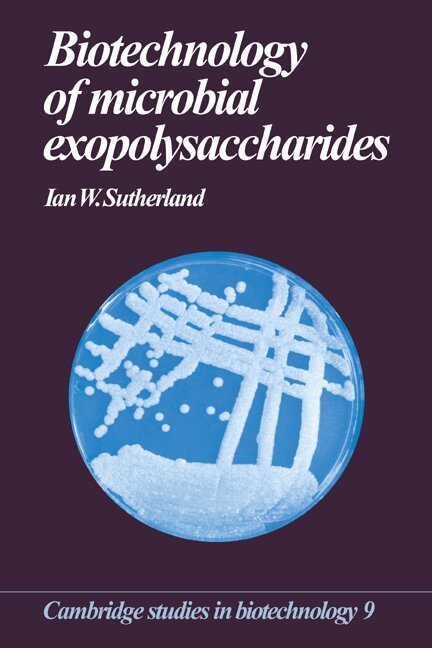

Ian W. Sutherland – författare
Visar alla böcker från författaren Ian W. Sutherland. Handla med fri frakt och snabb leverans.
3 produkter
3 produkter
Del 9 - Cambridge Studies in Biotechnology
Biotechnology of Microbial Exopolysaccharides
Häftad, Engelska, 2008
591 kr
Skickas inom 7-10 vardagar
This volume provides a thorough account of the structure and synthesis of microbial exopolysaccharides and of their widespread application across a broad range of industries, including food, oil and medicine. The successful exploitation of these polysaccharides requires a sound scientific understanding of their chemical and physical properties and also their biochemistry and biosynthesis; this volume covers all these aspects in a concise and coherent way. Interest in these polysaccharides has been fuelled by their increasing use in food, in the oil industry and in medicine. The author provides an account of all these areas as well as looking further ahead to speculate how their unique properties might be harnessed for future products and processes.
Del 9 - Cambridge Studies in Biotechnology
Biotechnology of Microbial Exopolysaccharides
Inbunden, Engelska, 1990
1 305 kr
Skickas inom 7-10 vardagar
This volume provides a thorough account of the structure and synthesis of microbial exopolysaccharides and of their widespread application across a broad range of industries, including food, oil and medicine. The successful exploitation of these polysaccharides requires a sound scientific understanding of their chemical and physical properties and also their biochemistry and biosynthesis; this volume covers all these aspects in a concise and coherent way. Interest in these polysaccharides has been fuelled by their increasing use in food, in the oil industry and in medicine. The author provides an account of all these areas as well as looking further ahead to speculate how their unique properties might be harnessed for future products and processes.
Häftad, Engelska, 1991
817 kr
Skickas inom 5-8 vardagar
The first edition of Microbial Physiology achieved sales in excess of 5,700 copies and earned the reputation of being the most up-to-date and concise introduction to the physiology of prokaryotic and eukaryotic microorganisms. This new edition maintains that reputation. Written primarily for undergraduate students in microbiology, the text offers a detailed description of the basic areas of microbial structure and metabolism and also covers the dynamic aspects of growth, control and development of microorganisms. There have been significant advances in the understanding of the eukaryotic genome and this new edition takes into account the implications of this for the biochemistry of morphogenesis in the microbial life cycle. Coverage of the new developments is supported by the addition of many new illustrations.